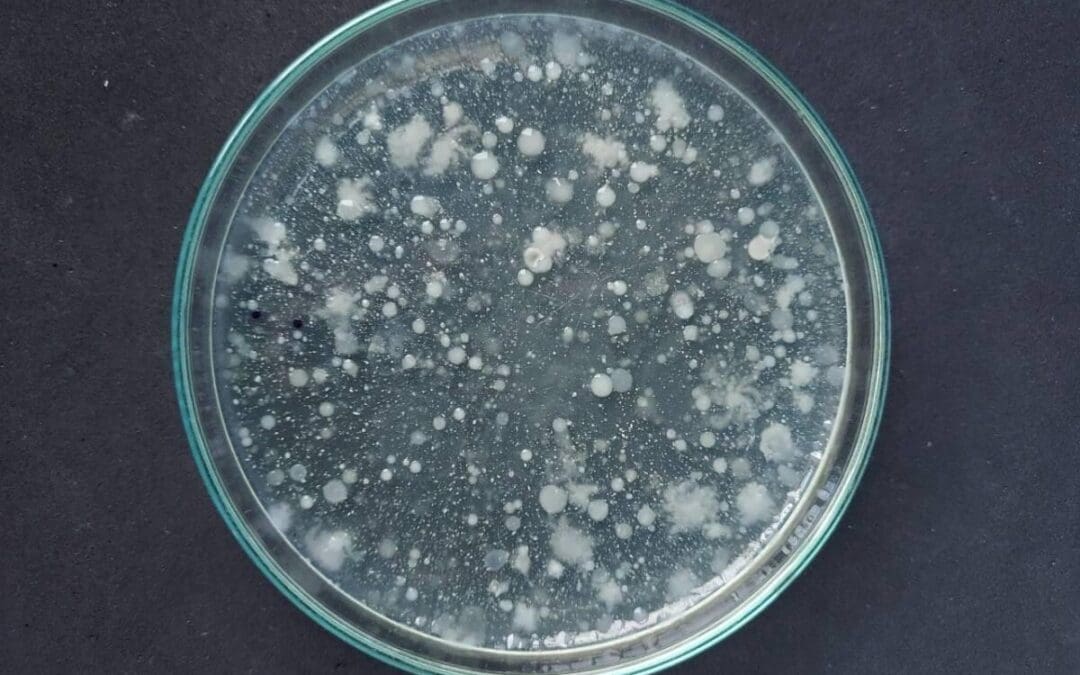
การอุดตันจากเชื้อจุลินทรีย์

เพื่อนช่าง RO
RO SOLUTION เป็นพื้นที่ของพวกเราช่าง RO ทุกท่านที่ดูแลและเดินระบบ RO พร้อมคลังความรู้ที่เป้นประโยชน์มากมายจากผู้มีประสบการณ์โดยตรง เพื่อเพื่อนช่างทุกท่าน
ทำไมต้อง RO-SOLUTION.INFO
ค้นหาข้อมูลตามที่ท่านต้องการ
เราได้รวบรวมข้อมูลความรู้ต่างๆ ที่เป็นประโยชน์ในการเดินระบบ ดูแล บำรุงรักษา จากผู้ผลิต membrane และรายงานการศึกษาวิจัย พัฒนาต่างๆจากทั่วโลก รวมถึงการแก้ปัญหาต่างๆของระบบให้แก่ท่าน
ข้อมูลและเอกสารในรูปแบบออนไลน์
ท่านสามารถดาวน์โหลดข้อมูลและเอกสารต่างๆไปใช้ได้ทุกที่ทุกเวลา
การบริการ
เราคือทีมที่มีประสบการณ์ที่ปฏิบัติงานจริง ทั้งงานติดตั้ง และงานซ่อมบำรุงมามากกว่า 30 ปี ที่พร้อมให้บริการเพื่อนช่างทุกท่านเพื่อ ให้เดินระบบได้อย่างมีประสิทธิภาพ
ติดต่อ สอบถาม หรือรับคำปรึกษา
เรายินดีตอบปัญหา ให้คำปรึกษาในการเดินระบบ การบำรุงรักษาและการแก้ไขปัญหาระบบ RO โดยไม่มีค่าใช้จ่าย
พื้นที่ของเพื่อนช่าง RO
ท่านสามารถใช้พื้นที่นี้ในการแชร์ประสบการณ์ และการแก้ไขปัญหาที่เป็นประโยชน์แก่เพื่อนช่าง RO ด้วยกันได้
คลังความรู้ต่าง ๆ
วิธีปรับปั๊มเคมีด้วยหลอดวัดอัตราการการป้อนสารเคมี
วิธีนี้จะเป็นวิธีที่แม่นยำที่สุดตามชนิดของสารเคมีที่ใช้และความดันของจุดที่ป้อน โดยในขณะที่ทำการปรับปั๊มนั้นระบบจะต้องเดินตามปกติ 1. เปิดวาล์ว 1,2,3 เพื่อเติมสารเคมีเข้าหลอดวัดอัตราการปั๊มจนเต็ม แล้วปิดวาล์ว 2 2. เดินระบบ RO และเดินปั๊มเคมีดูดเคมีจากหลอดวัดอัตราการปั๊ม 3. จับเวลาการลดของสารเคมีในหลอดแล้วปรับอัตราการปั๊มจนได้อัตราการปั๊มตามที่ต้องการ 4. เปิดวาล์ว 2 และปิดวาล์ว 3 5. การปรับอัตราการปั๊มในลักษณะนี้จะทำให้มั่นใจว่าได้ปั๊มสารเคมีเข้าระบบตามที่คำนวณไว้อย่างแน่นอนเพราะเป็นการปรับด้วยสารเคมีจริง แรงดันขณะใช้งานจริง
การทำโพรบบิ้ง (Probing)
กรณีที่ค่าความนำไฟฟ้าของน้ำ RO เพิ่มขึ้นผิดปกติโดยที่น้ำป้อนมีค่าความนำไฟฟ้าเท่าเดิม เราสามารถหาเมมเบรนท่อนที่มีปัญหาได้ด้วยการทำโพรบบิ้ง โดยการนำท่อสายยางขนาด 2 หุนสอดเข้าท่อน้ำ RO ย้อนกลับไปจากท่อที่ 6 จนถึงท่อที่ 1 เมื่อสอดเข้าไปจนสุดแล้วให้เดินระบบ RO แล้วเก็บน้ำ RO ที่ไหลออกมาจากสายยางมาวัดค่าความนำไฟฟ้าแล้วบันทึกไว้แล้วค่อยๆดึงสายยางออกมาครั้งละประมาณ 50 ซ.ม. แล้วเก็บน้ำมาวัดค่าความนำไฟฟ้าทุกครั้งที่ดึงสายยางออกมา ในภาพที่ 3 จะเห็นว่าค่าความนำไฟฟ้าของน้ำROที่ได้จากเมมเบนรนท่อนที่ 3 กระชากสูงขึ้นมากแสดงว่าเมมเบรนท่อนที่ 3 เป็นท่อนที่มีปัญหา หมายเหตู : ในกรณีที่ระบบ RO มีเวสเซลจำนวนมากให้ทำการหาก่อนว่าเวสเซลใดมีปัญหาโดยเก็บน้ำ RO ของแต่ละเวสเซลมาวัดค่าความนำไฟฟ้าก่อนแล้วจึงคัดเลือกที่จะทำโพรบบิ้งกับเวสเซลที่มีค่าความนำไฟฟ้าสูงผิดปกติ
ตารางสาเหตุของปัญหา RO
ตารางสาเหตุของปัญหา หมายเหตุ: เอกสารชดุ นแี้ ปลมาจาก RO Manual by DOW Chemical Company DOWNLOAD ตารางคลิ๊กที่นี่
การหาค่าสารคลอรีนอิสระตกค้าง(FRC) ในน้ำป้อน RO
การหาค่าสารคลอรีนอิสระตกค้าง(FRC)ในน้ำป้อน RO ในกระบวนการผลิตน้ำ ป้อนให้ระบบ RO. สิ่งสำคัญอย่างหนึ่งคือ การกำจัด คลอรีน ออกจากน้ำที่จะป้อนให้ระบบ RO. วิธีหนึ่งที่นิยมใช้กันมากคือ การนำน้ำมาผ่านกระบวนการกรองผ่าน ถัง Carbon. เพื่อกำจัด คลอรีน ออกให้มากที่สุด เพราะถ้า มีคลอรีน หลุดออกไปเข้าระบบ RO จะทำอันตรายให้กับ หน้าเมมเบรน จนถึงกับทำให้รูหน้าเมมเบรน ฉีกขาดได้ ในกรณีศึกษาของ บริษัทหนึ่ง ทางบริษัท ได้นำน้ำจากบ่อพักมาทำการป้อนให้ระบบ RO. โดยมีการเติม คลอรีนในระบบ และได้ทำการกำจัดออก โดยกระบวนการกรองผ่าน ถัง คาร์บอน และถังเรซิน ก่อนถึงจะป้อนให้ระบบ RO เรามาดูกันว่า เขากรอง คลอรีนออกได้แค่ไหน ที่สำคัญ ในน้ำที่ป้อนระบบ RO ควรที่จะไม่มี FRC ออกมาในระบบ คือ 0.00…
วิธีการวัด SDI
เตรียมอุปกรณ์ ล้างอุปกรณ์หัวกรองต่างๆให้สะอาด รวมทั้ง o-ring วางกระดาษกรองอย่างระมัดระวัง พยายามไม่ให้โดนนิ้วมือ ระวัง air purge ใน filter housing วิธีทดสอบ ไล่อากาศใน filter holder ก่อน วางกระบอกตวงให้อยู่ใต้หัวกรองเพื่อรองน้ำที่ผ่านกระดาษกรองมา ปรับ pressure ให้ได้ 30 psi แล้วกดlock ที่ pressure regulator เปิด valve ให้น้ำไหลผ่านอย่างต่อเนื่อง พร้อมจับเวลาเป็นวินาทีทันทีที่เริ่มต้นเปิด valve ( Ti ) โดยทำการบันทึกค่าเวลาที่อ่านได้ เมื่อน้ำครบ 100 ml และ 500 ml ปล่อยให้น้ำไหลผ่านกระดาษกรองอย่างต่อเนื่องต่อไปจนสิ้นสุดการทดสอบ จับเวลาเหมือนข้อ 4 ( Tf )เมื่อน้ำผ่านกระดาษกรองครบ 5 ,…
วิธีผสมสารเคมี
ก่อนที่จะเข้าในรายละเอียดวิธีผสมสารเคมี ขอให้ทำความเข้าใจกับความหมายต่างๆที่เกี่ยวข้องดังนี้คือ ผสมสารเคมีแบบ น้ำหนัก/ปริมาตร (w/v)หมายถึงการชั่งสารเคมีเป็นน้ำหนักเช่น 1 กิโลกรัมแล้วเทลงผสมกับสารละลาย เช่นน้ำ แล้วเมื่อผสมเรียบร้อยแล้วจะต้องวัดปริมาตรของสารละลายนั้นออกมาปริมาตรรวม เช่น 100 ลิตร ในการผสมสารละลายแบบนี้มีขั้นตอนในการเตรียมเป็นสามขั้นตอนคือในขั้นแรกให้เติมน้ำในถังผสมประมาณ 50-75% ของปริมาตรน้ำที่จะใช้ผสม แล้วชั่งสารเคมีตามน้ำหนักที่คำนวณไว้แล้วเทลงในถังผสมแล้วกวนให้เข้ากันให้ดี สุดท้ายต้องเติมน้ำจนได้ปริมาตรของสารผสมครบตามที่คำนวณไว้ ผสมสารเคมีแบบ น้ำหนัก/น้ำหนัก (w/w)หมายถึงการชั่งสารเคมีเป็นน้ำหนักเช่น 1 กิโลกรัมและชั่งสารละลายเช่นน้ำ 99 กิโลกรัมแล้วเททลงผสมในถังผสม หลังจากการกวนให้เข้ากันให้ดีแล้วสารผสมดังกล่าวจะมีน้ำหนัก 100 กิโลกรัมส่วนจะมีปริมาตรเท่าไหร่ก็เท่านั้น ผสมสารเคมีแบบ ปริมาตร/ปริมาตร (v/v)หมายถึงการตวงสารเคมีเป็นลิตรเช่น 1 ลิตรและชั่งสารละลาย เช่นน้ำ 99 ลิตรแล้วเทลงผสมในถังผสม หลังจากกวนให้เข้ากันให้ดีแล้วสารผสมดังกล่าวจะมีปริมาตร 100 ลิตรส่วนจะมีน้ำหนักเท่าไหร่ก็เท่านั้น หมายเหตู : ในการผสมสารเคมีที่ใช้ในวงการระบบบำบัดน้ำนั้นส่วนใหญ่จะเป็นการผสมแบบน้ำหนัก/ปริมาตร (w/v) เนื่องจากการป้อนสารเคมีที่ผสมแล้วเข้าไปยังระบบจะปั๊มเข้าไปเป็นปริมาตร เช่น 500 ซีซี/ชั่วโมง , 1 ลิตร/ชั่วโมง ฯลฯ…
วิธีปรับปั๊มเคมี
ปั๊มเคมีจะระบุอัตราการปั๊มสูงสุด (ลิตร/ชั่วโมง) ที่แรงดันสูงสุด(บาร์) ที่ป้ายเนมเพลท เช่น 1 ลิตร/ชั่งโมง 16 บาร์ นั่นคือปั๊มตัวนี้จะปั๊มได้ 1.1 ลิตร/ชั่วโมง ที่แรงดัน 16 บาร์ โดยใช้น้ำเป็นมาตรฐาน แต่ถ้านำไปปั๊มสารเคมีที่มีค่าความถ่วงจำเพาะไม่เท่ากับน้ำอัตราการปั๊มก็จะเปลี่ยนแปลงไป หมายเหตู : ความถ่วงจำเพาะของน้ำ = 1 ปั๊มเคมีที่มีมาตรฐานดีจะมีปุ่มปรับอัตราการปั๊ม 2 ปุ่ม โดยปุ่มแรกใช้ปรับความถี่ในการปั๊มของไดอะแฟรม 0-100 % (ปรับได้แบบต่อเนื่อง 0-100% แต่ต้องปรับตอนปั๊มเดินอยู่) และปุ่มที่สองใช้ปรับช่วงชักสั้นยาวของไดอะแฟรม 0-100 %(ปรับคลิกละ 25%) แต่ปั๊มเคมีที่มีเฉพาะปุ่มปรับช่วงชักสั้นยาวของไดอะแฟรมก็สามารถใช้งานได้ดีเช่นกัน(ปรับได้แบบต่อเนื่อง 0-100%) หมายเหตุ : ปั๊มเคมีที่มีปุ่มปรับ 2 ปุ่มจะมีข้อดีกว่ารุ่นที่มีปุ่มปรับเพียงปุ่มเดียวในบางกรณีดังจะกล่าวต่อไป การปรับอัตราปั๊มของปั๊มเคมีขนาด 1 ลิตร/ชั่วโมงที่แรงดัน 16 บาร์ให้ปั๊มได้ 0.6 ลิตร/ชั่วโมงที่แรงดัน 16…
การล้าง RO เมมเบรน
1. เมื่อไหร่จึงต้องทำการล้าง เราจะพิจารณาทำการล้างเมื่อเกิดสิ่งใดสิ่งหนึ่งดังนี้คือ น้ำ RO ที่ผลิตได้ลดลง 10% ตัวอย่างเช่น ปกติระบบผลิตน้ำได้ที่ 20 คิวต่อชั่วโมงเมื่อเดินระบบต่อเนื่องน้ำ ROที่ผลิตได้จะลดลงเรื่อยจนเหลือ 18 คิวต่อชั่วโมง ( ลดลง 2 คิวต่อชั่วโมง = ลดลง 10% ของ 20 คิวต่อชั่วโมง) ให้ทำการล้าง ค่าความนำไฟฟ้าของน้ำ RO เพิ่มขึ้น 5-10 % ในขณะที่ค่าความนำพไฟฟ้าของน้ำป้อนเท่าเดิม ตัวอย่างเช่น ปกติค่าความนำไฟฟ้าของน้ำป้อน = 300 ไมโครซีเมนต์ต่อเซ็นติเมตรและค่าความดันไฟฟ่าของน้ำ RO ที่ผลิตได้ = 15 ไมโครซีเมนต์ต่อเซ็นติเมตรเมื่อเดินระบบต่อเนื่องค่าความนำไฟฟ้าของน้ำ RO ที่ผลิตได้จะค่อยๆสูงขึ้นจนถึง 15.75-16.5 ไมโครซีเมนต์ต่อเซนติเมตร ( เพิ่มขึ้น 0.75-1.5 ไมโครซีเมนต์ต่อเซนติเมตร =…
ตารางบันทึกการเดินระบบอาร์โอ
การบันทึกข้อมูลที่เกี่ยวข้องกับการเดินระบบอาร์โอนั้น จะทำให้เราสามารถติดตามสังเกตประสิทธิภาพการทำงานของระบบroได้ การบันทึกค่าต่างๆลงในตารางบันทึกเป็นเครื่องมือที่มีค่ามากสำหรับการประเมิน และแก้ไขปัญหาต่างๆในอนาคต รวมถึงยังเป็นข้อมูลที่จำเป็นในกรณีที่จะต้องมีการเคลมตามการรับประกันระบบจากผู้ขายอีกด้วย รายงานการสตาร์ทระบบหลังการติดตั้ง การบันทึกข้อมูลรายงานการเดินระบบROหลังติดตั้ง ควรมีข้อมูลที่ประกอบด้วย รายละเอียดระบบทั้งหมด แผนภูมิขั้นตอน อุปกรณ์ เครื่องกรองต่างๆที่ประกอบอยู่ในระบบทั้งหมด (Flow diagram) ,เครื่องมือวัด ,รายการวัสดุ , แหล่งน้ำดิบ ,ระบบบำบัดน้ำทั้งก่อนและหลังRO จนถึงจุดใช้งาน ผลการเดินระบบตามรายการ (checklist) ประกอบการทดสอบระบบหลังติดตั้งตามคำแนะนำของผู้ผลิต ผลการสอบเทียบอุปกรณ์เครื่องมือ เกจวัดวัดค่าต่างๆตามคำแนะนำของผู้ผลิต บันทึกประสิธิภาพ ผลการทำงานของ ระบบ RO และระบบบำบัด ในการเดินระบบครั้งแรกตามข้อมูลในข้อ 2 ค่าการเดินระบบRO เราควรบันทึกค่าต่างๆในการเดินระบบROอย่างน้อยกะละ 1 ครั้ง โดยประกอบไปด้วยข้อมูลต่างๆดังนี้ (ตัวอย่างตารางบันทึกแนบท้าย) วันที่ เวลา ชั่วโมงการทำงานของระบบ ค่าแรงดันของน้ำที่ลดลงระหว่างจุดเข้าและออกจากไส้กรอง , จุดเข้าและออกจากเมมเบรนแต่ละสเตจ ค่าแรงดันของน้ำป้อนRO ,น้ำRO, น้ำทิ้งแต่ละสเตจ ค่าอัตราการไหลของน้ำROและน้ำทิ้งแต่ละสเตจ ค่าความนำไฟฟ้า, ค่าของแข็งละลายน้ำของน้ำป้อนRO…
การเก็บรักษา Membrane ระหว่างการหยุดผลิต
หากระบบ Reverse Osmosis (RO) , Nanofiltraion (NF) , Ultrafiltration (UF) จำเป็นต้องหยุดการผลิต (Shutdown) เป็นเวลานานเกินกว่า 48 ชั่วโมง จำเป็นต้องทำการเก็บรักษา (Preserve) เพื่อป้องกันการเจริญเติบโตของเชื้อจุลินทรีย์ ซึ่งจะก่อให่เกิดการอุดตันใน Membrane ก่อนการหยุดระบบ ควรทำการล้างระบบ (CIP) ก่อนการหยุดผลิตและเก็บรักษา หลังจากล้างเมมเบรนแล้ว ภายในไม่เกิน 10 ชั่วโมงให้ทำการขั้นตอนดังนี้ แช่เมมเบรนใน pressure vessel ด้วย โซเดียมเมตาไบซัลไฟต์ความเข้มข้น 0-1.5% โดยการป้อนสารละลายนี้เข้าสู่ระบบ และทำให้สารละลายนี้ล้นออกมาเพื่อไล่อากาศ (Overflow Technique)หมุนเวียนสารละลายโซเดียมเมตาไบซัลไฟต์ จนสารละลายล้นออกจากจุดท่สูงที่สุดของเวสเซล (Pressure vessel ) เพื่อไล่อากาศให้เหลือน้อยที่สุด และมีสารละลายอยู่เต็มเวสเซล (Pressure vessel) ปิดวาล์วไล่อากาศ (Air vent) ให้หมด…
กรณีศึกษา
การหาค่า FRC. ในกระบวนการผลิตน้ำ ที่มีผลต่อ เครื่องผลิตน้ำ RO
ในกระบวนการผลิตน้ำ ป้อนให้ระบบ RO. สิ่งสำคัญอย่างหนึ่งคือ การกำจัด คลอรีน ออกจากน้ำที่จะป้อนให้ระบบ RO. วิธีหนึ่งที่นิยมใช้กันมากคือ การนำน้ำมาผ่านกระบวนการกรองผ่าน ถัง Carbon. เพื่อกำจัด คลอรีน ออกให้มากที่สุด เพราะถ้า มีคลอรีน หลุดออกไปเข้าระบบ RO จะทำอันตรายให้กับ หน้าเมมเบรน จนถึงกับทำให้รูหน้าเมมเบรน ฉีกขาดได้ ในกรณีศึกษาของ บริษัทหนึ่ง ทางบริษัท ได้นำน้ำจากบ่อพักมาทำการป้อนให้ระบบ RO. โดยมีการเติม คลอรีนในระบบ และได้ทำการกำจัดออก โดยกระบวนการกรองผ่าน ถัง คาร์บอน และถังเรซิน ก่อนถึงจะป้อนให้ระบบ RO เรามาดูกันว่า เขากรอง คลอรีนออกได้แค่ไหน ที่สำคัญ ในน้ำที่ป้อนระบบ RO ควรที่จะไม่มี FRC ออกมาในระบบ คือ 0.00 ppm น้ำก่อนเข้าถัง…
การอุดตันจากเชื้อจุลินทรีย์
รายละเอียดระบบ ระบบบำบัดน้ำทิ้งเพื่อนำกลับมาใช้ใหม่ (Water Recycle Plant ) แห่งหนึ่งในนิคมอุตสาหกรรม มีระบบ RO 4 ชุดอัตราการผลิตรวม 10,000 คิวบิกเมตรต่อวัน ซึ่งน้ำป้อนคือน้ำเสียรวมของโรงงานอุตสาหกรรมต่างๆ ในนิคมอุตสาหกรรมที่ได้รับการบำบัดจนได้มาตรฐานน้ำทิ้งของกรมโรงงาน อุตสาหกรรมแล้ว นำมาผ่านระบบ กำจัดตะกอนอีกครั้งด้วยถังตกตะกอนแล้วผ่านถังกรองทรายแล้วเข้าเก็บยังถังน้ำป้อน ปัญหา หลังจากเริ่มเดินระบบไม่นานพบว่าเกิดการอุดตันขึ้นอย่างรวดเร็วกับระบบ RO ทั้ง 4 ชุด ทำให้ต้องทำการล้าง RO เมมเบรนอย่างต่อเนื่องหมุนเวียนกันไปทุกวัน คือ วันจันทร์ทำการล้างชุดที่ 1 วันอังคารทำการล้างชุดที่ 1 วันพุทธทำการล้างชุดที่ 3 วันพฤหัสทำการล้างชุดที่ 4 แล้วพอวันศุกร์ก็กลับมาล้างชุดที่ 1 หมุนเวียนกันไป ทำให้ ไม่สามารถผลิตน้ำได้ตามที่ต้องการ สิ้นเปลืองเวลาและสารเคมีที่ใช้ในการล้างอย่างมาก สำรวจระบบและแก้ไขปัญหา จากปรสบการณ์ที่ทางทีมงานมีมายาวนานการอุดตันที่เกิดขึ้นอย่างรวดเร็วกับระบบ RO นั้นส่วนใหญ่จะมาจาก เชื้อจุลินทรีย์เนื่องจากเชื้อจุลินทรีย์จะมีการแบ่งตัวเจริญเติบโตได้อย่างรวดเร็วในสภาพแวดล้อมที่เหมาะสมดัง เช่นใน RO เมมเบรน…
กรณีศึกษา
รายละเอียดระบบ ลูกค้าเป็นโรงงานอุตสาหกรรม ซึ่งใช้นํ้าที่ผลิตจากระบบรีเวิร์สออสโมซิส เพื่อใช้ในขบวนการผลิต , ป้อนเข้าระบบหม้อไอนํ้าและป้อนเข้าระบบหล่อย็น โรงงานใช้นํ้าจากคลองเป็นแหล่งนํ้าดิบ โดยผ่านกระบวนการตกตะกอนในถังตกตะกอน (CLARIFIER)จากนั้นจึงนํามาผ่านถังกรองทรายกรองความขุ่น ถังกรองคาร์บอนเพื่อกําจัดคลอรีน ถังเรซินเพื่อลดความกระด้าง ถุงกรองผ้าและไส้กรองขนาด 5 ไมครอนและ 1 ไมครอน โรงงานมีระบบอาร์โอ 2 ชุด ชุดที่ 1 ออกแบบเพื่อผลิตนํ้า 20 คิวบิกเมตรต่อชั่วโมง , 1 สเตจ ประกอบด้วยเมมเบรน 18 ท่อน ซึ่งติดตั้งอยู่ใน 4 เวสเซลๆ ละ 6 ท่อน ชุดที่ 2 ติดตั้งห่างจากชุดแรกหลายปีเพื่อผลิตนํ้า 30 คิวบิกเมตรต่อชั่วโมง , 2 สเตจจัดเรียงแบบ 4:2 เวสเซล คือสเตจ 14 เวสเซลๆละ 5…